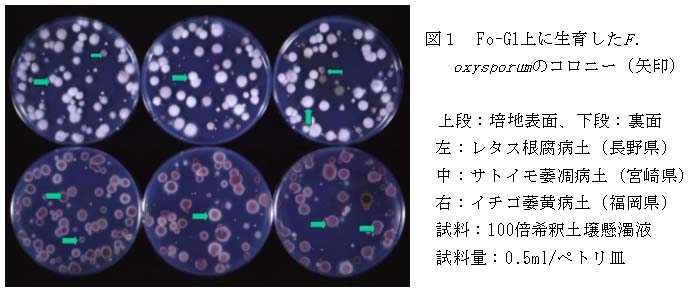

Fusarium oxysporum及び硝酸塩代謝能欠損菌株の選択培地
-
[要約]
- Fusarium oxysporum用の選択培地(Fo-G1とFo-G2)と同菌の硝酸塩代謝能欠損菌株用の選択培地(Fo-N1とFo-N2)は、5倍以上に希釈した土壌懸濁液からそれぞれの菌株を分離することができる。
- [キーワード]
- 選択培地、Fusarium oxysporum、硝酸塩代謝能欠損菌株
- [担当]
- 九州沖縄農研・野菜花き研究部・野菜花き保護研究チーム
[連絡先]0942-43-8271
[区分]九州沖縄農研・病害虫、共通基盤・病害虫、野菜茶業・野菜生産環境
[分類]科学・普及
-
[背景・ねらい]
- サラダナ根腐病は低い病原菌密度で発病することが明らかになり、また、Fusarium用の駒田培地及び硝酸塩代謝能欠損(nit)菌株用の選択培地Fo-Nの成分であるPCNBが製造中止になった。このためPCNBを含まず、F. oxysporum及びnit菌株を低〜高希釈の土壌懸濁液から分離できる新しい選択培地を開発する。
-
[成果の内容・特徴]
-
- F. oxysporum用のFo-G1とFo-G2、nit菌株用のFo-N1とFo-N2の組成を表1に示した。F. oxysporum及び雑菌の生育は土壌栄養により異なるため、試料が100倍希釈以上の土壌懸濁液の時にFo-G1とFo-N1、5または10倍希釈土壌懸濁液の時にFo-G2とFo-N2を使用する。Fo-G培地にはnit菌株も生育する。
- F. oxysporumのコロニー裏面は通常赤紫色で、色素非生産菌は肌色を呈する。F. solani、F.moniliforme、Penicilliumなど、土壌によってはCylindrocarponまたはPaecilomycesが生育するが、F.oxysporumは色と形により識別できる(図1、Fo-G1の事例)。
- 硝酸エコナゾールはPenicillium属菌、L-ソルボースは接合菌、イミノクタジン酢酸塩液剤はTrichoderma属菌、トルクロフォスメチル水和剤はSyncephalastrum sp.、ホウ酸はF. solaniの生育を抑制するために添加した。F. oxysporumのコロニーは硝酸エコナゾールの増量で小さくなり、イミノクタジン酢酸塩液剤の増量でまとまり、ホウ酸の減量により生育旺盛になる。
-
[成果の活用面・留意点]
-
- F. oxysporumのコロニーが小さいか雑菌が多い土壌では、上記3を参考にして成分量を変更する。表1の()の範囲で、病原性F. oxysporumのペトリ皿当りのコロニー数に差はなかった。
- Fo-N1の場合、微量要素液を添加しても回収率の低いnit菌株があった。このため100倍希釈を越える土壌懸濁液試料に1〜2%の殺菌土を加えて使用する。土壌懸濁液試料に殺菌土を加えるのであればFo-G1の微量要素液を除くことができる。
-
培地分注後3〜5日間、無風暗所に置いて培地表面を乾燥する。直径9cmのペトリ皿当り0.5〜1mlの土壌懸濁液試料を培地の表面に広げる。水分が培地に速やかに吸収されない場合は、クリーンベンチ内で送風により水分を減じる。
-
[具体的データ]
-

表1 4種選択培地の組成
図1 Fo-G1上に生育したF. oxysporumのコロニー(矢印)
-
[その他]
-
研究課題名:レタス根腐病の発病抑制技術の開発、その他
予算区分 :経常、行政対応特研(レタス)
研究期間 :1998〜2001年度
目次へ戻る